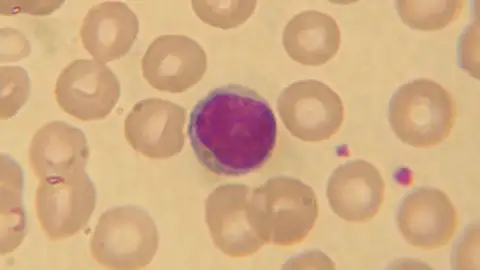
Crean un nuevo método para proteger al cuerpo de enfermedades autoinmunes Crean un nuevo método para proteger al cuerpo de enfermedades autoinmunes

23:07 MIN
Cosas de la vida: ¿Cómo aparecen las enfermedades en el ser humano?
El Doctor Carlos López Otín habla en Julia en la Onda de cómo aparecen las enfermedades en el ser humano. Explica cómo las células de cada persona ponen a funcionar unos u otros genes para regular "todo lo que nos pasa".
Temas
- Julia en la Onda
- Carlos López Otín
- Cosas de la vida



